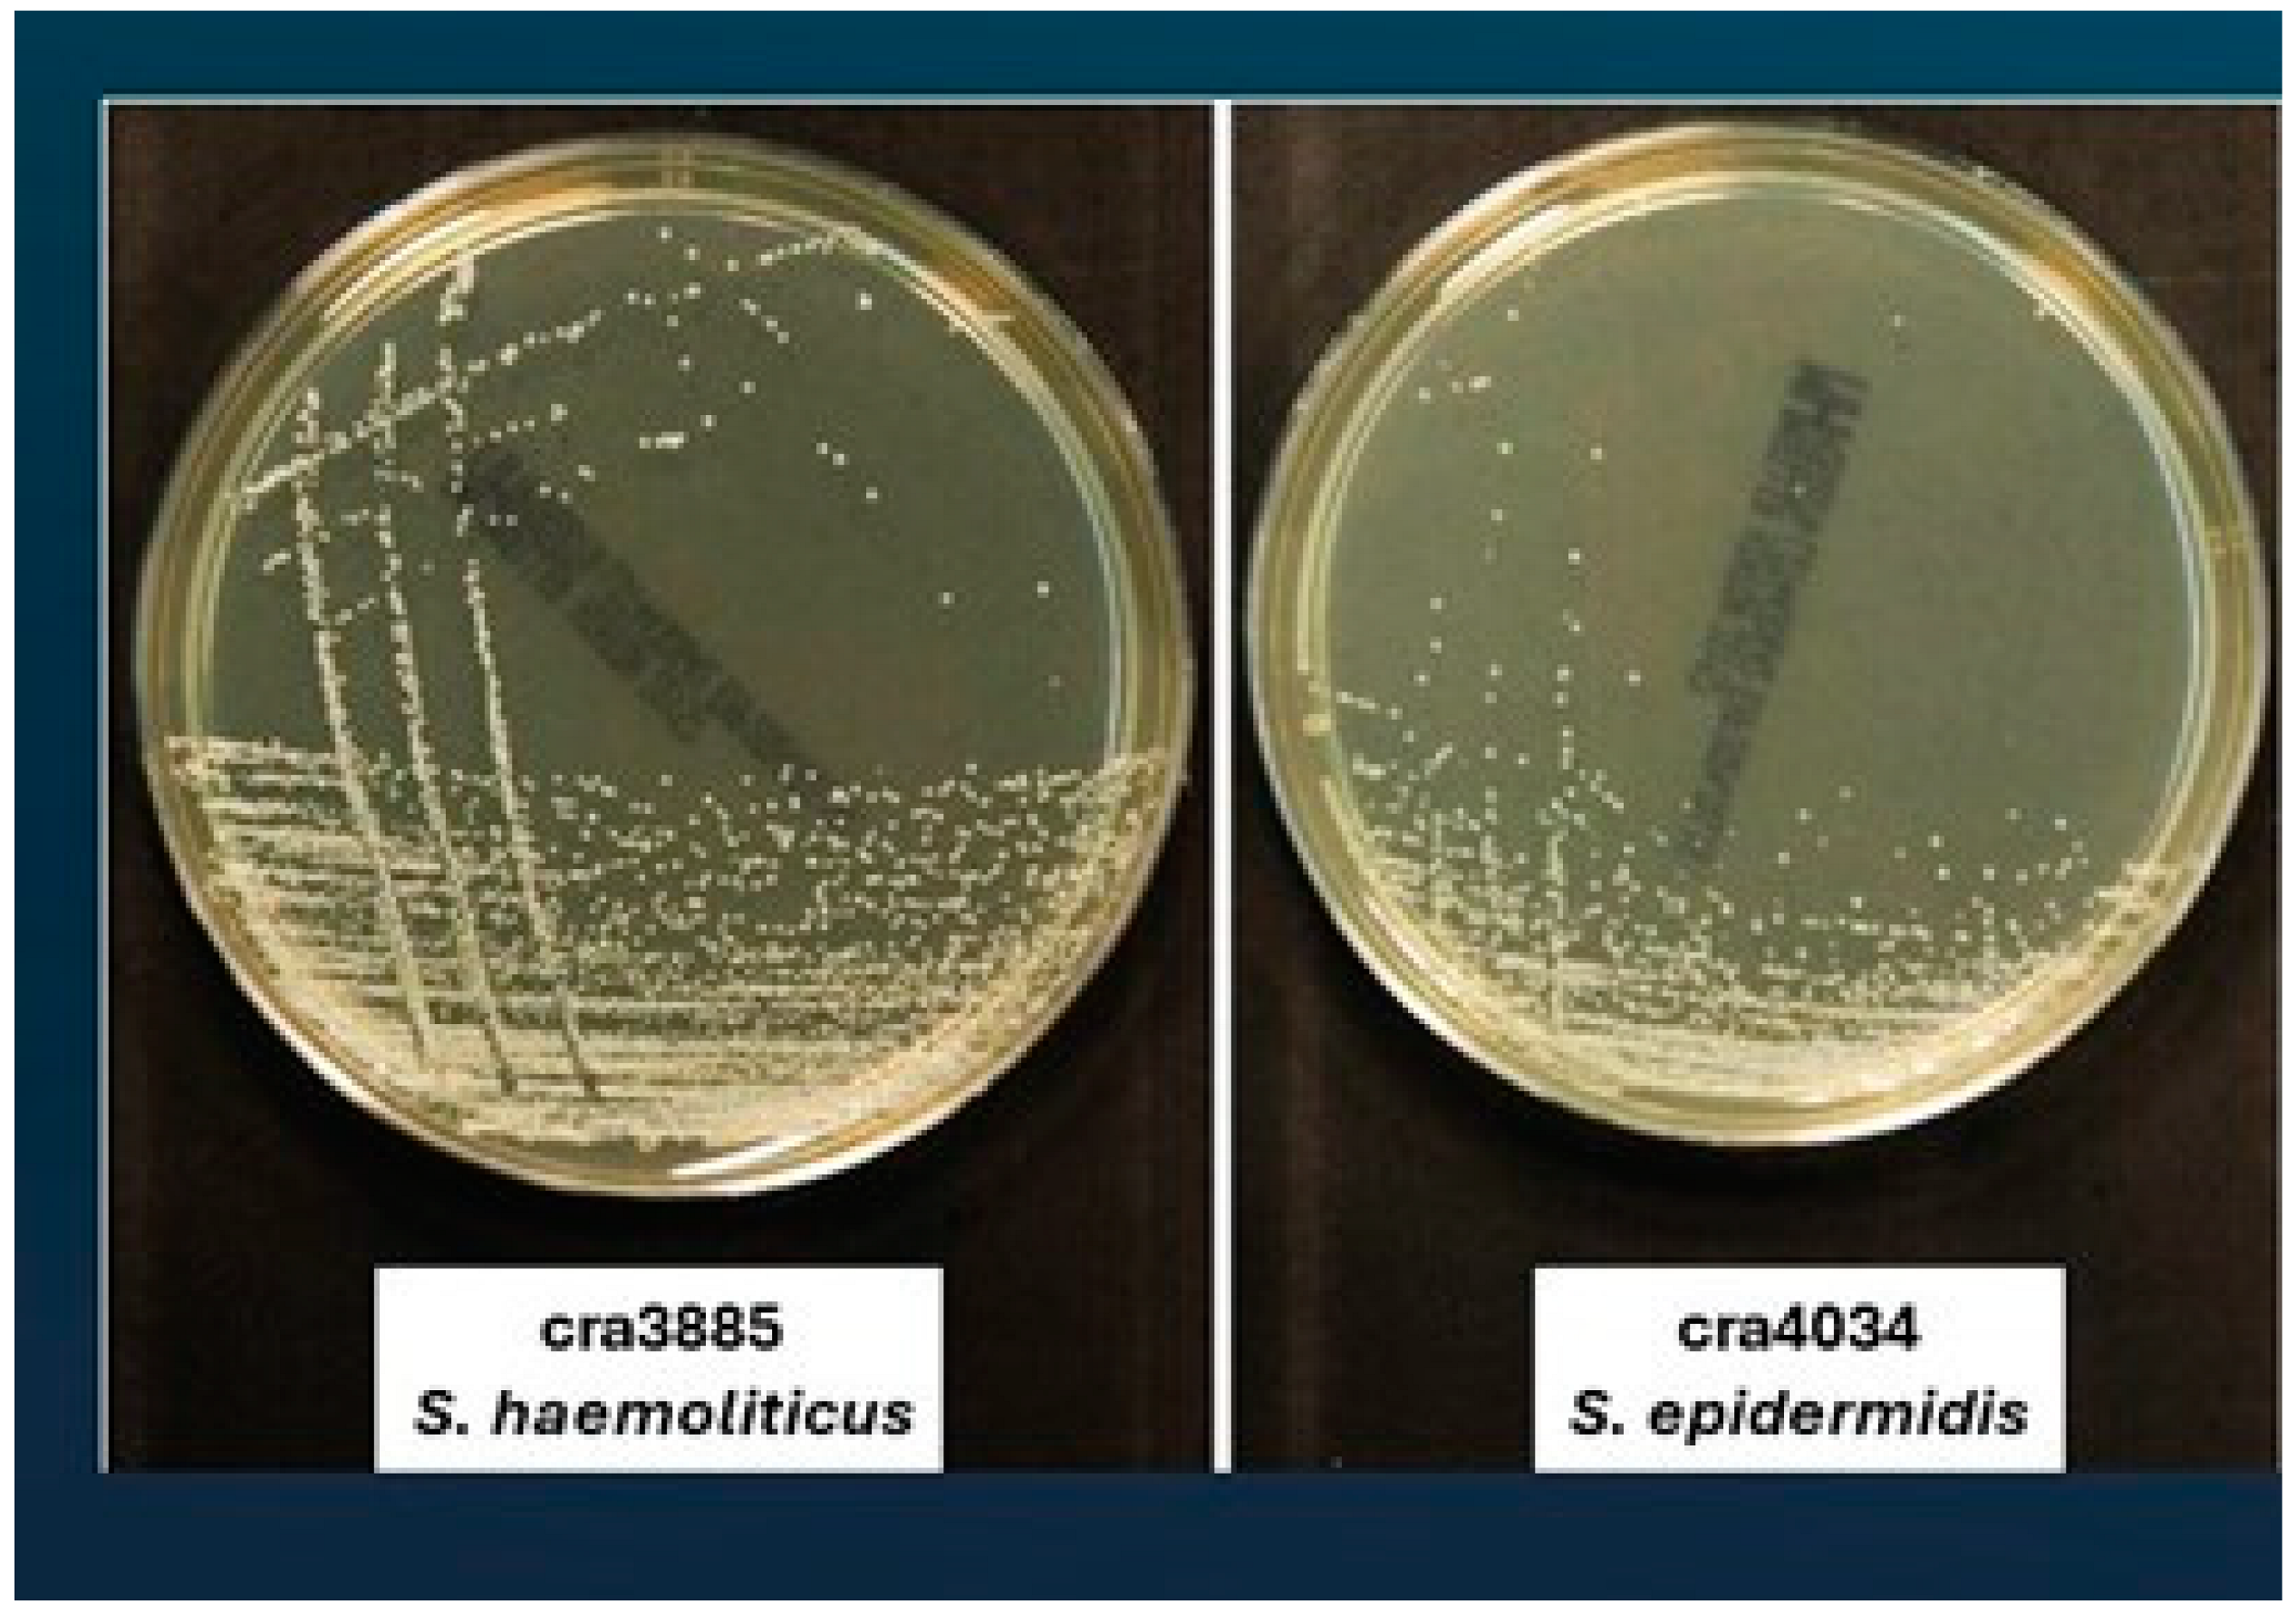
Antibiotics 13 00972 g001a Antibiotics 13 00972 g001a
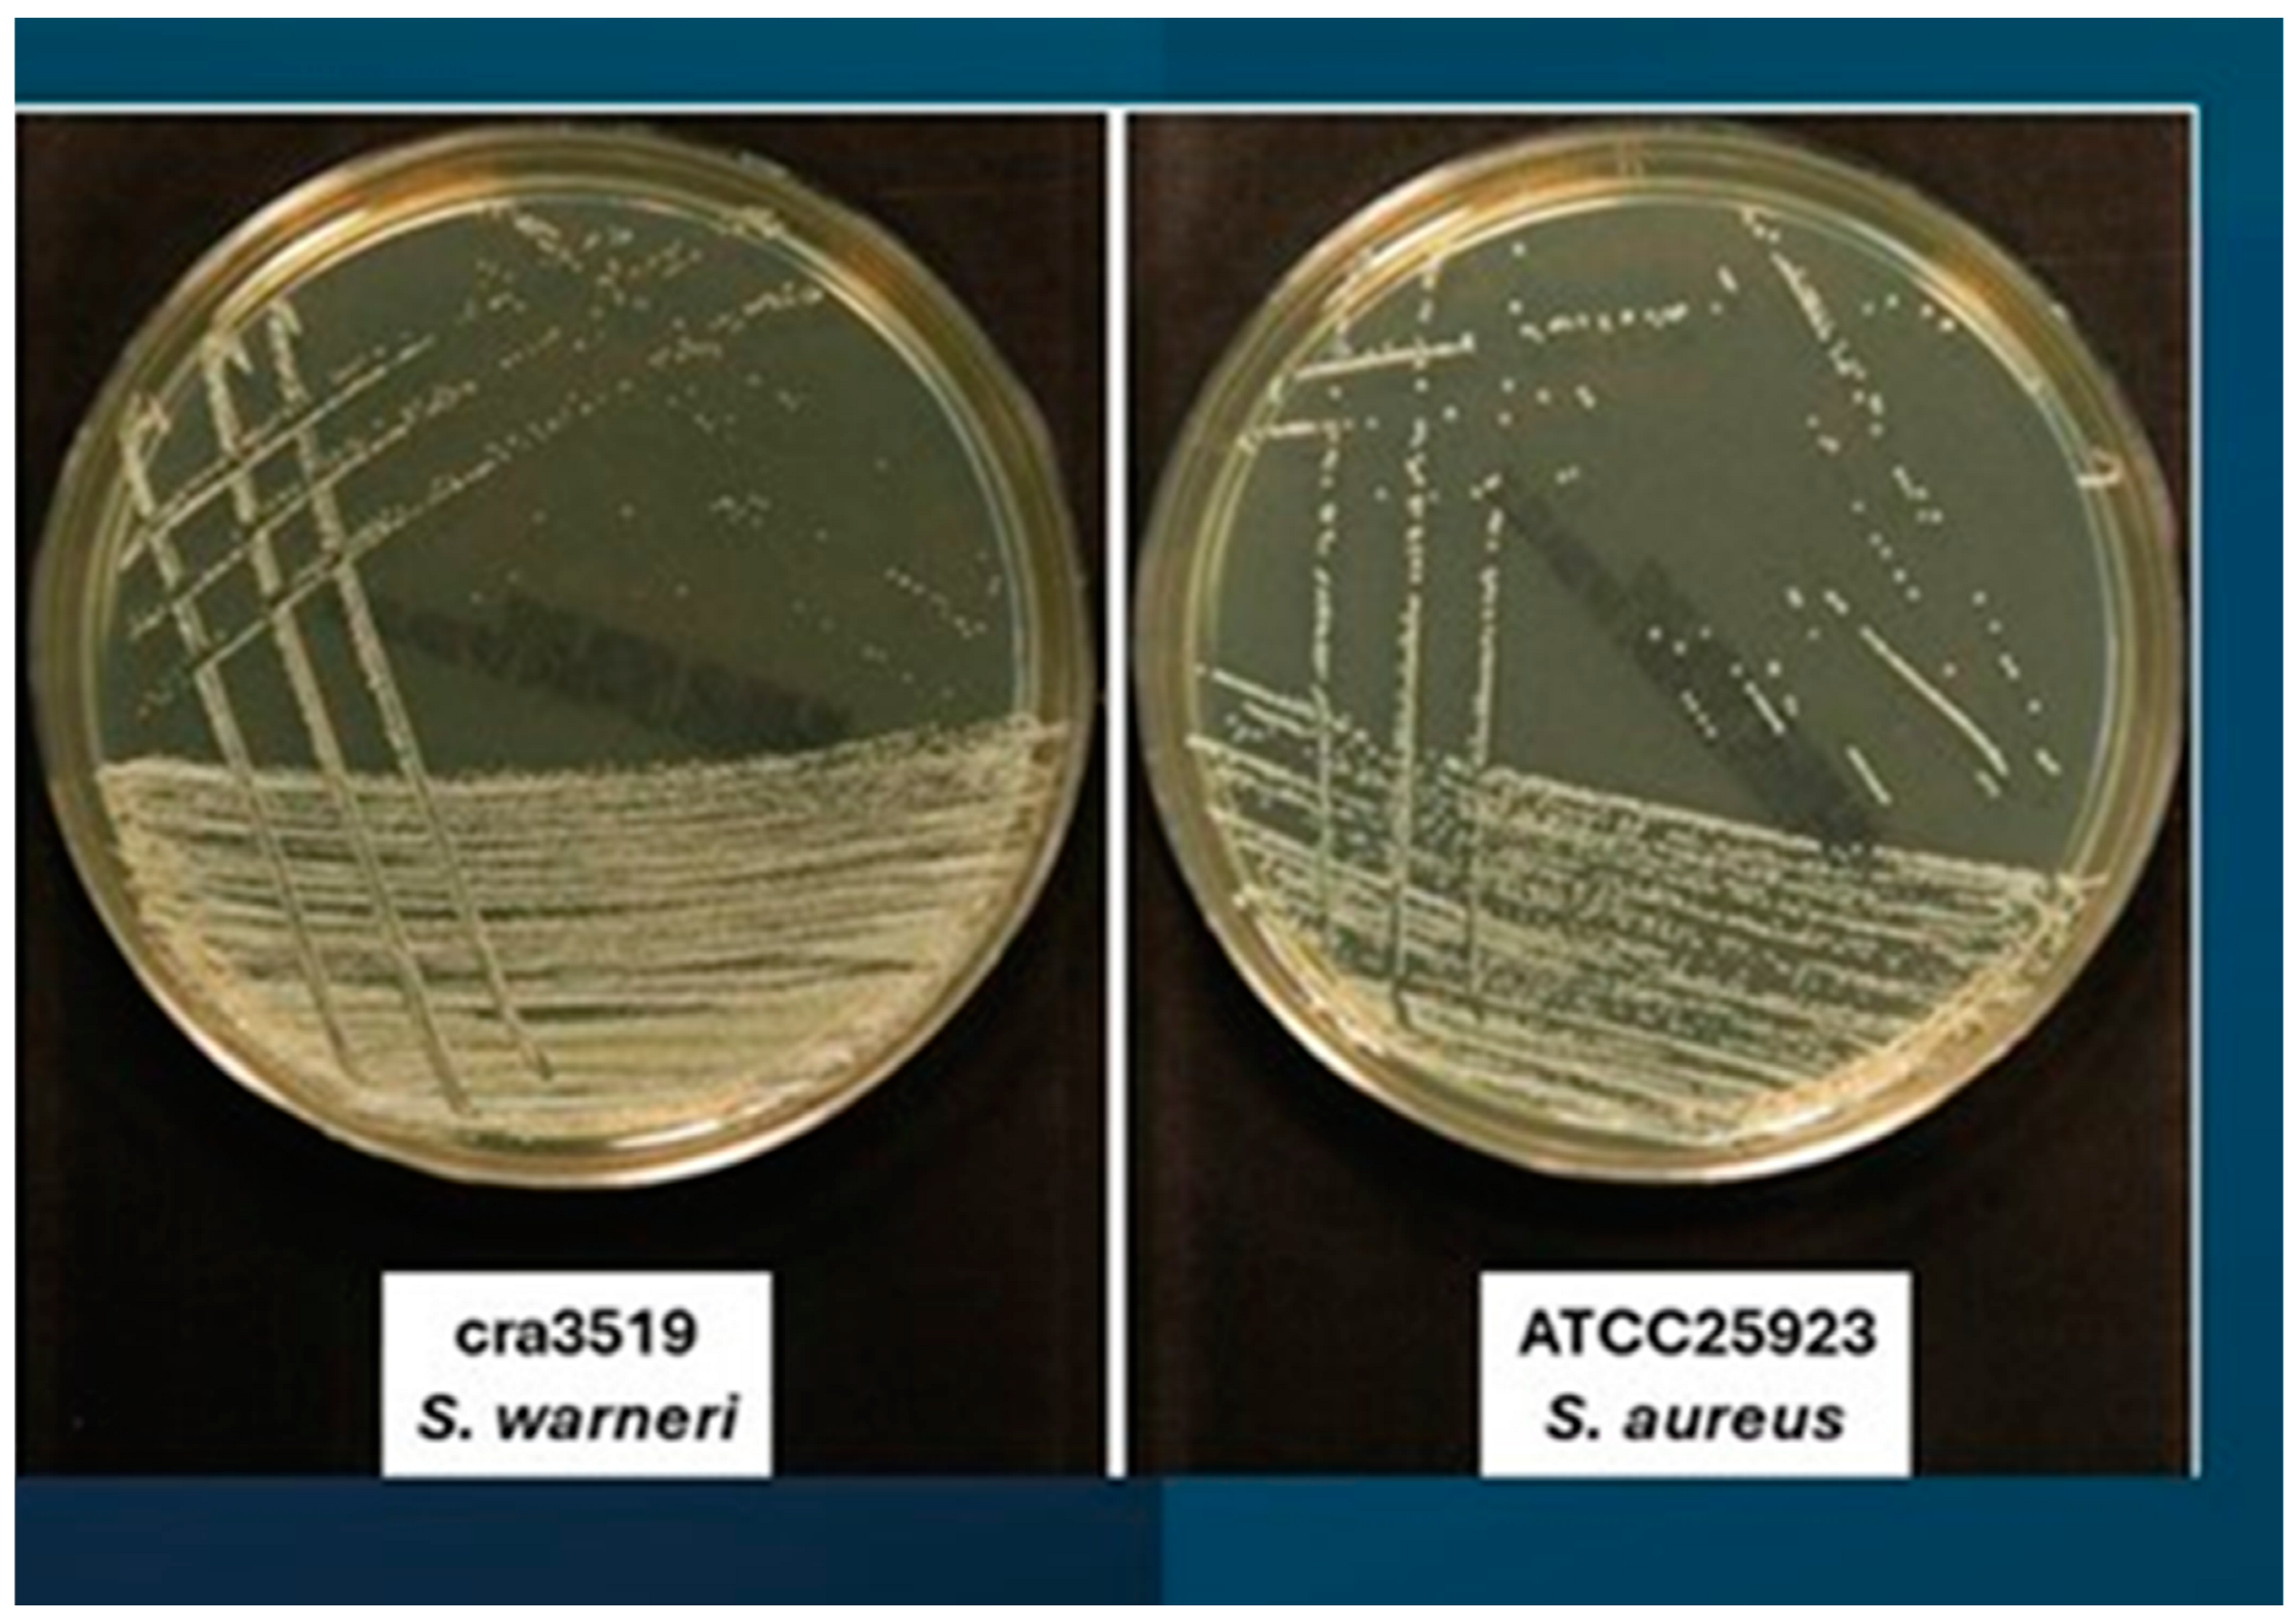
Antibiotics 13 00972 g001b Antibiotics 13 00972 g001b

The Opportunistic Pathogen Staphylococcus warneri: Virulence and Antibiotic Resistance, Clinical Features, Association with Orthopedic Implants and Other Medical Devices, and a Glance at Industrial Applications
Abstract
1. Introduction
2. Identification
3. Clinical Aspects
3.1. Bacteraemia
3.2. Native Valve Endocarditis (NVE)
3.3. Orthopedic Implant Infections
3.4. Vertebral Osteomyelitis
3.5. Septic Arthritis
3.6. Discitis
3.7. Botryomycosis
3.8. Neonatal Intensive Care Unit (NICU)
3.9. Cerebrospinal Fluid Shunt Infections (CSF)
3.10. Bacterial Ventriculitis
3.11. Sepsis
3.12. Urinary Tract Infection
3.13. Meningitis
3.14. Veterinary Field
3.15. The One Health Approach
3.16. Food Field and Correalated Antibiotic Resistance Issues
4. Pathological Characteristics
5. Antibiotic Resistance and Antibiotic Therapy
6. Industrial and Commercial Objectives
7. Materials and Methods
Author Contributions
Funding
Institutional Review Board Statement
Informed Consent Statement
Data Availability Statement
Acknowledgments
Conflicts of Interest
References
- Torre, D.; Ferraro, G.; Fiori, G.P.; Martegani, R.; Speranza, F.; Tambini, R.; Zeroli, C. Ventriculoatrial Shunt Infection Caused by Staphylococcus warneri: Case Report and Review. Clin. Infect. Dis. 1992, 14, 49–52. [Google Scholar] [CrossRef] [PubMed]
- Younger, J.J.; Christensen, G.D.; Bartley, D.L.; Simmons, J.C.H.; Barrett, F.F. Coagulase-negative staphylococci isolated from cerebrospinal fluid shunts: Importance of slime production, species identification, and shunt removal. J. Infect. Dis. 1987, 156, 548–554. [Google Scholar] [CrossRef] [PubMed]
- Kawamura, Y.; Hou, X.G.; Sultana, F.; Hirose, H.; Miyake, M.; Shu, S.E.; Ezaki, T. Distribution of Staphylococcus species among human clinical specimens and emended description of Staphylococcus caprae. J. Clin. Microbiol. 1998, 36, 2038–2042. [Google Scholar] [CrossRef] [PubMed]
- Kloos, W.E.; Schleifer, K.H. Isolation and characterization of staphylococci from human skin II. Descriptions of four new species: Staphylococcus warneri, Staphylococcus capitis, Staphylococcus hominis, and Staphylococcus simulans. Int. J. Syst. Bacteriol. 1975, 25, 62–79. [Google Scholar] [CrossRef]
- Balows, A.; Hausler, W.J., Jr.; Herrmann, K.L.; Isenberg, H.D.; Shadomy, H.J. Manual of Clinical Microbiology, 5th ed.; American Society for Microbiology: Washington, DC, USA, 1991; 1384p. [Google Scholar]
- Regecová, I.; Výrostková, J.; Zigo, F.; Gregová, G.; Pipová, M.; Jevinová, P.; Becová, J. Detection of Resistant and Enterotoxigenic Strains of Staphylococcus warneri Isolated from Food of Animal Origin. Foods 2022, 11, 1496. [Google Scholar] [CrossRef]
- Rasmussen, T.T.; Kirkeby, L.P.; Poulsen, K.; Reinholdt, J.; Kilian, M. Resident aerobic microbiota of the adult human nasal cavity. APMIS 2000, 108, 663–675. [Google Scholar] [CrossRef] [PubMed]
- Ohara-Nemoto, Y.; Haraga, H.; Kimura, S.; Nemoto, T.K. Occurrence of staphylococci in the oral cavities of healthy adults and nasal oral trafficking of the bacteria. J. Med. Microbiol. 2008, 57, 95–99. [Google Scholar] [CrossRef]
- Kloos, W. Natural populations of the genus Staphylococcus. Ann. Rev. Microbial. 1980, 34, 559–592. [Google Scholar] [CrossRef]
- Cimiotti, J.P.; Haas, J.P.; Della-Latta, P.; Wu, F.; Saiman, L.; Larson, E.L. Prevalence and clinical relevance of Staphylococcus warneri in the neonatal intensive care unit. Infect. Control Hosp. Epidemiol. 2007, 28, 326–330. [Google Scholar] [CrossRef]
- Mehr, S.S.; Sadowsky, J.L.; Doyle, L.W.; Carr, J. Sepsis in neonatal intensive care in the late 1990s. J. Paediatr. Child Health 2002, 38, 246–251. [Google Scholar] [CrossRef]
- Seng, R.; Kitti, T.; Thummeepak, R.; Kongthai, P.; Leungtongkam, U.; Wannalerdsakun, S.; Sitthisak, S. Biofilm formation of methicillin-resistant coagulase negative staphylococci (MR-CoNS) isolated from community and hospital environments. PLoS ONE 2017, 12, e0184172. [Google Scholar] [CrossRef] [PubMed]
- Arciola, C.R.; An, Y.H.; Campoccia, D.; Donati, M.E.; Montanaro, L. Etiology of implant orthopedic infections: A survey on 1027 clinical isolates. Int. J. Artif. Organs. 2005, 28, 1091–1100. [Google Scholar] [CrossRef]
- El-Ashker, M.; Gwida, M.; Monecke, S.; Ehricht, R.; Elsayed, M.; El-Gohary, F.; Reißig, A.; Müller, E.; Paul, A.; Igbinosa, E.O.; et al. Microarray-based detection of resistance genes in coagulase-negative staphylococci isolated from cattle and buffalo with mastitis in Egypt. Trop. Anim. Health Prod. 2020, 52, 3855–3862. [Google Scholar] [CrossRef] [PubMed]
- Sivaraman, G.K.; Vijayan, A.A.; Visnuvinayagam, S.; Muthulakshmi, T.; Prasad, M.M.; Ravishankar, C.N. Incidence of multi drug resistant coagulase-negative Staphylococci from seafood samples, Veraval, Gujarat. Indian J. Anim. Health 2022, 61, 65–70. [Google Scholar] [CrossRef]
- Yılmaz, D.K.; Berik, N. Phenotypic and Genotypic Antibiotic Resistance of Staphylococcus warneri and Staphylococcus pasteuri Isolated from Stuffed Mussels. Aquat. Sci. Eng. 2024, 39, 172–178. [Google Scholar] [CrossRef]
- Alves, E.; Esteves, A.C.; Correia, A.; Cunha, Â.; Faustino, M.A.; Neves, M.G.; Almeida, A. Protein profiles of Escherichia coli and Staphylococcus warneri are altered by photosensitization with cationic porphyrins. Photochem. Photobiol. Sci. 2015, 14, 1169–1178. [Google Scholar] [CrossRef]
- Kamath, U.; Singer, C.; Isenberg, H.D. Clinical significance of Staphylococcus warneri bacteraemia. J. Clin. Microbiol. 1992, 30, 261–264. [Google Scholar] [CrossRef]
- Wood, C.A. Significant infection caused by Staphylococcus warneri. J. Clin. Microbiol. 1992, 30, 2216–2217. [Google Scholar] [CrossRef]
- Buttery, J.P.; Easton, M.; Pearson, S.R.; Hogg, G.G. Pediatric bacteremia due to Staphylococcus warneri: Microbiological, epidemiological, and clinical features. J. Clin. Microbiol. 1997, 35, 2174–2177. [Google Scholar] [CrossRef]
- Announ, N.; Mattei, J.P.; Jaoua, S.; Fenollar, F.; Sati, H.; Chagnaud, C.; Roudier, J.; Guis, S. Multifocal discitis caused by Staphylococcus warneri. Jt. Bone Spine 2004, 71, 240–242. [Google Scholar] [CrossRef]
- Stöllberger, C.; Wechsler-Fördös, A.; Geppert, F.; Gulz, W.; Brownstone, E.; Nicolakis, M.; Finsterer, J. Staphylococcus warneri endocarditis after implantation of a lumbar disc prosthesis in an immunocompetent patient. J. Infect. 2006, 52, e15–e18. [Google Scholar] [CrossRef]
- Arslan, F.; Saltoglu, N.; Mete, B.; Mert, A. Recurrent Staphylococcus warnerii prosthetic valve endocarditis: A case report and review. Ann. Clin. Microbiol. Antimicrob. 2011, 10, 4. [Google Scholar] [CrossRef] [PubMed]
- Legius, B.; Landuyt, K.V.; Verschueren, P.; Westhovens, R. Septic arthritis due to Staphylococcus warneri: A diagnostic challenge. Open Rheumatol. J. 2012, 6, 310–311. [Google Scholar] [CrossRef] [PubMed][Green Version]
- Azimi, T.; Mirzadeh, M.; Sabour, S.; Nasser, A.; Fallah, F.; Pourmand, M.R. Coagulase-negative staphylococci (CoNS) meningitis: A narrative review of the literature from 2000 to 2020. New Microbes New Infect. 2020, 37, 100755. [Google Scholar] [CrossRef] [PubMed]
- Kini, G.D.; Patel, K.; Parris, A.R.; Tang, J.S. An Unusual Presentation of Endocarditis Caused by Staphylococcus warneri. Open Microbiol. J. 2010, 4, 103–105. [Google Scholar] [CrossRef]
- Kloos, W.E.; Bannerman, T.L. Update on clinical significance of coagulase-negative staphylococci. Clin. Microbiol. Rev. 1994, 7, 117–140. [Google Scholar] [CrossRef]
- Tan, T.Y.; Ng, S.Y.; Ng, W.X. Clinical significance of coagulase-negative staphylococci recovered from nonsterile sites. J. Clin. Microbiol. 2006, 44, 3413–3414. [Google Scholar] [CrossRef][Green Version]
- Barigye, R.; Schaan, L.; Gibbs, P.S.; Schamber, E.; Dyer, N.W. Diagnostic evidence of Staphylococcus warneri as a possible cause of bovine abortion. J. Vet. Diagn. Investig. 2007, 19, 694–696. [Google Scholar] [CrossRef]
- Espino, L.; Bermudez, R.; Fidalgo, L.E.; González, A.; Miño, N.; Quiroga, M.I. Meningoencephalitis associated with Staphylococcus warneri in a dog. J. Small Anim. Pract. 2006, 47, 598–602. [Google Scholar] [CrossRef]
- Musharrafieh, R.; Tacchi, L.; Trujeque, J.; LaPatra, S.; Salinas, I. Staphylococcus warneri, a resident skin commensal of rainbow trout (Oncorhynchus mykiss) with pathobiont characteristics. Vet. Microbiol. 2014, 169, 80–88. [Google Scholar] [CrossRef]
- Gil, P.; Vivas, J.; Gallardo, C.S.; Rodriguez, L.A. First isolation of Staphylococcus warneri, from diseased rainbow trout, Oncorhynchus mykiss (Walbaum), in Northwest Spain. J. Fish Dis. 2000, 23, 295–298. [Google Scholar] [CrossRef]
- Schmidt, T.; Kock, M.M.; Ehlers, M.M. Diversity and antimicrobial susceptibility profiling of staphylococci isolated from bovine mastitis cases and close human contacts. J. Dairy Sci. 2015, 98, 6256–6269. [Google Scholar] [CrossRef] [PubMed]
- Xiao, Z.; Xue, M.; Wu, X.; Zeng, L.; Zhu, Y.; Jiang, N.; Fan, Y.; Zhou, Y. Isolation and identification of Staphylococcus warneri from diseased Coreius guichenoti. Aquac. Rep. 2022, 22, 100988. [Google Scholar] [CrossRef]
- Louail, R.; Florin, F.; Bernard, S.; Michaud, J.B.; Breton, J.; Achamrah, N.; Tavolacci, M.P.; Coëffier, M.; Ribet, D. Invasion of intestinal cells by Staphylococcus warneri, a member of the human gut microbiota. Gut Pathog. 2023, 15, 4. [Google Scholar] [CrossRef]
- Huang, T.Y.; Lim, H.L. Electrogenic Staphylococcus warneri in lactate-rich skin. Biochem. Biophys. Res. Commun. 2022, 618, 67–72. [Google Scholar] [CrossRef]
- Phukon, M.; Sahu, P.; Srinath, R.; Nithya, A.; Babu, S. Unusual Occurrence of Staphylococcus warneri as Endophyte in Fresh Fruits along with Usual Bacillus spp. J. Food Saf. 2013, 33, 102–106. [Google Scholar] [CrossRef]
- Kianpour, S.; Ebrahiminezhad, A.; Deyhimi, M.; Negahdaripour, M.; Raee, M.J.; Mohkam, M.; Rezaee, H.; Irajie, C.; Berenjian, A.; Ghasemi, Y. Structural characterization of polysaccharide-coated iron oxide nanoparticles produced by Staphylococcus warneri, isolated from a thermal spring. J. Basic Microbiol. 2019, 59, 569–578. [Google Scholar] [CrossRef]
- Gelman, R.; Potruch, A.; Oster, Y.; Ishay, Y.; Gur, C.; Beeri, R.; Strahilevitz, J. Native aortic valve Staphylococcus warneri endocarditis after COVID-19 infection: A case report and a review of literature. APMIS 2022, 130, 270–275. [Google Scholar] [CrossRef]
- Gory, L.; Millet, L.; Godon, J.J.; Montel, M.C. Identification of Staphylococcus carnosus and Staphylococcus warneri isolated from meat by fluorescent in situ hybridization with 16S rRNA-targeted oligonucleotide probes. Syst. Appl. Microbiol. 1999, 22, 225–228. [Google Scholar] [CrossRef]
- Iwase, T.; Seki, K.; Shinji, H.; Mizunoe, Y.; Masuda, S. Development of a real-time PCR assay for the detection and identification of Staphylococcus capitis, Staphylococcus haemolyticus and Staphylococcus warneri. J. Med. Microbiol. 2007, 56, 1346–1349. [Google Scholar] [CrossRef][Green Version]
- Hirotaki, S.; Sasaki, T.; Kuwahara-Arai, K.; Hiramatsu, K. Rapid and accurate identification of human- associated staphylococci by use of multiplex PCR. J. Clin. Microbiol. 2011, 49, 3627–3631. [Google Scholar] [CrossRef] [PubMed]
- Campoccia, D.; Montanaro, L.; Visai, L.; Corazzari, T.; Poggio, C.; Pegreffi, F.; Maso, A.; Pirini, V.; Ravaioli, S.; Cangini, I.; et al. Characterization of 26 Staphylococcus warneri isolates from orthopedic infections. Int. J. Artif. Organs. 2010, 33, 575–581. [Google Scholar] [CrossRef] [PubMed]
- Rajani, R.; Klein, J.L. Infective endocarditis: A contemporary update. Clin. Med. 2020, 20, 31–35. [Google Scholar] [CrossRef] [PubMed]
- Diaconu, R.; Golumbeanu, E.; Constantin, A.; Donoiu, I. Native valve endocarditis with Staphylococcus warneri. BMJ Case Rep. 2019, 12, e229546. [Google Scholar] [CrossRef] [PubMed]
- El Nakadi, N.; El Nakadi, B. Native valve endocarditis caused by Staphylococcus warneri: An unusual presentation. Acta Cardiol. 2021, 76, 318–319. [Google Scholar] [CrossRef] [PubMed]
- Bhardwaj, B.; Bhatnagar, U.B.; Conaway, D.G. An Unusual Presentation of Native Valve Endocarditis Caused by Staphylococcus warneri. Rev. Cardiovasc. Med. 2016, 17, 140–143. [Google Scholar] [CrossRef]
- Dan, M.; Marien, G.J.; Goldsand, G. Endocarditis caused by Staphylococcus warneri on a normal aortic valve following vasectomy. Can. Med. Assoc. J. 1984, 131, 211–213. [Google Scholar] [PubMed]
- Yamamoto, J.; Endo, A.; Sugawara, H.; Izumi, T.; Takahashi, K.; Yamamoto, S.; Akiyama, M.; Adachi, O.; Kaneko, K.; Sawada, S.; et al. Native Valve Endocarditis due to Staphylococcus warneri Developing in a Patient with Type 1 Diabetes. Intern. Med. 2020, 59, 2269–2274. [Google Scholar] [CrossRef]
- Kurihara, I.; Yoshida, K.; Fukuchi, T.; Sugawara, H. Native mitral valve infective endocarditis caused by Staphylococcus warneri: A case-based review. Clin. Case Rep. 2021, 9, e04476. [Google Scholar] [CrossRef]
- Alawad, M.J.; Ali, G.A.; Goravey, W. Underrecognized pathogen; Staphylococcus warneri-associated native mitral valve endocarditis in an immunocompetent host: A case report and literature review. Clin. Case Rep. 2022, 10, e05591. [Google Scholar] [CrossRef]
- Karthigasu, K.T.; Bowman, R.A.; Grove, D.I. Vertebral osteomyelitis due to Staphylococcus warneri. Ann. Rheum. Dis. 1986, 45, 1029–1030. [Google Scholar] [CrossRef] [PubMed]
- Yendo, T.M.; Valente, N.S.; Nico, M.M.S. Botryomycosis caused by Staphylococcus warneri: The first case reported. Int. J. Dermatol. 2021, 60, 509–511. [Google Scholar] [CrossRef] [PubMed]
- Martínez-Lage, J.F.; Martínez-Lage Azorín, L.; Almagro, M.J. Staphylococcus warneri ventriculoperitoneal shunt infection: Failure of diagnosis by ventricular CSF sampling. Childs Nerv. Syst. 2010, 26, 1795–1798. [Google Scholar] [CrossRef] [PubMed]
- Bakhaidar, M.; Wilcox, J.T.; Sinclair, D.S.; Diaz, R.J. Ventriculoatrial Shunts: Review of Technical Aspects and Complications. World Neurosurg. 2022, 158, 158–164. [Google Scholar] [CrossRef]
- Şimşek, F.; Yevgi, R.; Yalçın, A. Primary Bacterial Ventriculitis caused by Staphylococcus warneri. Rev. Soc. Bras. Med. Trop. 2023, 56, e0631–e2022. [Google Scholar] [CrossRef]
- Purcarea, A.; Sovaila, S. Sepsis, a 2020 review for the internist. Rom. J. Intern. Med. 2020, 58, 129–137. [Google Scholar] [CrossRef]
- Ivić, I.; Karanović, J.; Pavičić-Ivelja, M. Sepsis with multiple abscesses caused by Staphylococcus warneri: A case report. Cent. Eur. J. Med. 2013, 8, 45–47. [Google Scholar] [CrossRef]
- Kanuparthy, A.; Challa, T.; Meegada, S.; Siddamreddy, S.; Muppidi, V. Staphylococcus warneri: Skin Commensal and a Rare Cause of Urinary Tract Infection. Cureus 2020, 12, e8337. [Google Scholar] [CrossRef] [PubMed]
- Incani, R.N.; Hernández, M.; Cortez, J.; González, M.E.; Salazar, Y.D. Staphylococcus warneri meningitis in a patient with Strongyloides stercoralis hyperinfection and lymphoma: First report of a case. Rev. Inst. Med. Trop. Sao Paulo 2010, 52, 169–170. [Google Scholar] [CrossRef]
- Pepi, M.; Focardi, S. Antibiotic-Resistant Bacteria in Aquaculture and Climate Change: A Challenge for Health in the Mediterranean Area. Int. J. Environ. Res. Public Health 2021, 18, 5723. [Google Scholar] [CrossRef]
- Sundin, G.W.; Wang, N. Antibiotic Resistance in Plant-Pathogenic Bacteria. Annu. Rev. Phytopathol. 2018, 56, 161–180. [Google Scholar] [CrossRef] [PubMed]
- Silva, V.; Caniça, M.; Ferreira, E.; Vieira-Pinto, M.; Saraiva, C.; Pereira, J.E.; Capelo, J.L.; Igrejas, G.; Poeta, P. Multidrug-Resistant Methicillin-Resistant Coagulase-Negative Staphylococci in Healthy Poultry Slaughtered for Human Consumption. Antibiotics 2022, 11, 365. [Google Scholar] [CrossRef] [PubMed]
- Chou, C.C.; Chen, L.F. Enterotoxin Production by Staphylococcus warneri CCRC 12929, a Coagulase-Negative strain. J. Food Prot. 1997, 60, 923–927. [Google Scholar] [CrossRef] [PubMed]
- Chajęcka-Wierzchowska, W.; Gajewska, J.; Zadernowska, A.; Randazzo, C.L.; Caggia, C. A Comprehensive Study on Antibiotic Resistance among Coagulase-Negative Staphylococci (CoNS) Strains Isolated from Ready-to-Eat Food Served in Bars and Restaurants. Foods 2023, 12, 514. [Google Scholar] [CrossRef] [PubMed]
- McEwen, S.A.; Collignon, P.J. Antimicrobial Resistance: A One Health Perspective. Microbiol. Spectr. 2018, 6. [Google Scholar] [CrossRef]
- Hoque, M.N.; Moyna, Z.; Faisal, G.M.; Das, Z.C. Whole-Genome Sequence of the Multidrug-Resistant Staphylococcus warneri Strain G1M1F, Isolated from Mice with Mastitis. Microbiol. Resour. Announc. 2023, 12, e0027523. [Google Scholar] [CrossRef]
- Price, S.B.; Flournoy, D.J. Comparison of antimicrobial susceptibility patterns among coagulase-negative staphylococci. Antimicrob. Agents Chemother. 1982, 21, 436–440. [Google Scholar] [CrossRef]
- Liu, C.; Zhao, X.; Xie, H.; Zhang, X.; Li, K.; Ma, C.; Fu, Q. Whole genome sequence and comparative genome analyses of multi-resistant Staphylococcus warneri GD01 isolated from a diseased pig in China. PLoS ONE 2020, 15, e0233363. [Google Scholar] [CrossRef]
- Nunes, A.P.F.; Teixeira, L.M.; Iorio, N.L.P.; Bastos, C.C.R.; Fonseca, L.D.; Souto-Padron, T.; Netto dos Santos, K.R. Heterogeneous resistance to vancomycin in Staphylococcus epidermidis, Staphylococcus haemolyticus and Staphylococcus warneri clinical strains: Characterisation of glycopeptide susceptibility profiles and cell wall thickening. Int. J. Antimicrob. Agents 2006, 27, 307–315. [Google Scholar] [CrossRef]
- Minamikawa, M.; Kawai, Y.; Inoue, N.; Yamazaki, K. Purification and characterization of Warnericin RB4, anti-Alicyclobacillus bacteriocin, produced by Staphylococcus warneri RB4. Curr. Microbiol. 2005, 51, 22–26. [Google Scholar] [CrossRef]
- Prema, P.; Bharathy, S.; Palavesam, A.; Sivasubramanian, M.; Immanuel, G. Detection, purification and efficacy of warnerin produced by Staphylococcus warneri. World J. Microbiol. Biotechnol. 2006, 22, 865–872. [Google Scholar] [CrossRef]
- Okuda, K.; Aso, Y.; Nagao, J.; Shioya, K.; Kanemasa, Y.; Nakayama, J.; Sonomoto, K. Characterization of functional domains of lantibiotic-binding immunity protein, NukH, from Staphylococcus warneri ISK-1. FEMS Microbiol. Lett. 2005, 250, 19–25. [Google Scholar] [CrossRef][Green Version]
- Sashihara, T.; Dan, M.; Kimura, H.; Matsusaki, H.; Sonomoto, K.; Ishizaki, A. The effect of osmotic stress on the production of nukacin ISK-1 from Staphylococcus warneri ISK-1. Appl. Microbiol. Biotechnol. 2001, 56, 496–501. [Google Scholar] [CrossRef]
- Sashihara, T.; Kimura, H.; Higuchi, T.; Adachi, A.; Matsusaki, H.; Sonomoto, K.; Ishizaki, A. A novel lantibiotic, nukacin ISK-1, of Staphylococcus warneri ISK-1: Cloning of the structural gene and identification of the structure. Biosci. Biotechnol. Biochem. 2000, 64, 2420–2428. [Google Scholar] [CrossRef]
- Aso, Y.; Okuda, K.; Nagao, J.; Kanemasa, Y.; Thi Bich Phuong, N.; Koga, H.; Shioya, K.; Sashihara, T.; Nakayama, J.; Sonomoto, K. A novel type of immunity protein, NukH, for the lantibiotic nukacin ISK-1 produced by Staphylococcus warneri ISK-1. Biosci. Biotechnol. Biochem. 2005, 69, 1403–1410. [Google Scholar] [CrossRef]
- Xie, G.; Cheng, Q.; Daligault, H.; Davenport, K.; Gleasner, C.; Jacobs, L.; Kubicek-Sutherland, J.; LeCuyer, T.; Otieno, V.; Raballah, E.; et al. Draft Genome Sequences of Two Staphylococcus warneri Clinical Isolates, Strains SMA0023-04 (UGA3) and SMA0670-05 (UGA28), from Siaya County Referral Hospital, Siaya, Kenya. Microbiol. Resour. Announc. 2019, 8, e01595-18. [Google Scholar] [CrossRef]
- Aso, Y.; Sashihara, T.; Nagao, J.; Kanemasa, Y.; Koga, H.; Hashimoto, T.; Higuchi, T.; Adachi, A.; Nomiyama, H.; Ishizaki, A.; et al. Characterization of a gene cluster of Staphylococcus warneri ISK-1 encoding the biosynthesis of and immunity to the lantibiotic, nukacin ISK-1. Biosci. Biotechnol. Biochem. 2004, 68, 1663–1671. [Google Scholar] [CrossRef]
- Okuda, K.; Aso, Y.; Nakayama, J.; Sonomoto, K. Cooperative transport between NukFEG and NukH in immunity against the lantibiotic nukacin ISK-1 produced by Staphylococcus warneri ISK-1. J. Bacteriol. 2008, 190, 356–362. [Google Scholar] [CrossRef]
- Aso, Y.; Koga, H.; Sashihara, T.; Nagao, J.; Kanemasa, Y.; Nakayama, J.; Sonomoto, K. Description of complete DNA sequence of two plasmids from the nukacin ISK-1 producer, Staphylococcus warneri ISK-1. Plasmid 2005, 53, 164–178. [Google Scholar] [CrossRef]
- Yokoi, K.J.; Kawahigashi, N.; Uchida, M.; Sugahara, K.; Shinohara, M.; Kawasaki, K.; Nakamura, S.; Taketo, A.; Kodaira, K. The two-component cell lysis genes holWMY and lysWMY of the Staphylococcus warneri M phage varphiWMY: Cloning, sequencing, expression, and mutational analysis in Escherichia coli. Gene 2005, 351, 97–108. [Google Scholar] [CrossRef]
- Héchard, Y.; Ferraz, S.; Bruneteau, E.; Steinert, M.; Berjeaud, J.M. Isolation and characterization of a Staphylococcus warneri strain producing an anti-Legionella peptide. FEMS Microbiol. Lett. 2005, 252, 19–23. [Google Scholar] [CrossRef] [PubMed]
- Verdon, J.; Berjeaud, J.M.; Lacombe, C.; Héchard, Y. Characterization of anti-Legionella activity of warnericin RK and delta-lysin I from Staphylococcus warneri. Peptides 2008, 29, 978–984. [Google Scholar] [CrossRef] [PubMed]
- Freitas, F.S.; Vidigal, P.M.P.; Siqueira, T.P.; de Barros, M.; Tótola, M.R. The draft genome of Staphylococcus warneri TRPF4, a bacteriocin producer with potent activity against the causative agent of Legionnaires’ Disease. 3 Biotech 2020, 10, 232. [Google Scholar] [CrossRef]
- Bogut, A.; Niedźwiadek, J.; Kozioł-Montewka, M.; Strzelec-Nowak, D.; Blacha, J.; Mazurkiewicz, T.; Marczyński, W.; Plewik, D. Characterization of Staphylococcus epidermidis and Staphyloccocus warneri small-colony variants associated with prosthetic-joint infections. J. Med. Microbiol. 2014, 63, 176–185. [Google Scholar] [CrossRef][Green Version]
- Szczuka, E.; Krzymińska, S.; Kaznowski, A. Clonality, virulence and the occurrence of genes encoding antibiotic resistance among Staphylococcus warneri isolates from bloodstream infections. J. Med. Microbiol. 2016, 65, 828–836. [Google Scholar] [CrossRef] [PubMed]
- Pietrocola, G.; Campoccia, D.; Motta, C.; Montanaro, L.; Arciola, C.R.; Speziale, P. Colonization and Infection of Indwelling Medical Devices by Staphylococcus aureus with an Emphasis on Orthopedic Implants. Int. J. Mol. Sci. 2022, 23, 5958. [Google Scholar] [CrossRef]
- Arciola, C.R.; Gamberini, S.; Campoccia, D.; Visai, L.; Speziale, P.; Baldassarri, L.; Montanaro, L. A multiplex PCR method for the detection of all five individual genes of ica locus in Staphylococcus epidermidis. A survey on 400 clinical isolates from prosthesis-associated infections. J. Biomed. Mater. Res. A 2005, 75, 408–413. [Google Scholar] [CrossRef] [PubMed]
- Peng, Q.; Tang, X.; Dong, W.; Sun, N.; Yuan, W. A Review of Biofilm Formation of Staphylococcus aureus and Its Regulation Mechanism. Antibiotics 2022, 12, 12. [Google Scholar] [CrossRef]
- Bowden, L.C.; Finlinson, J.; Jones, B.; Berges, B.K. Beyond the double helix: The multifaceted landscape of extracel-lular DNA in Staphylococcus aureus biofilms. Front. Cell Infect. Microbiol. 2024, 14, 1400648. [Google Scholar] [CrossRef]
- Passerini, L.; Phang, P.T.; Jackson, F.L.; Lam, K.; Costerton, J.W.; King, E.G. Biofilms on right heart flow-directed catheters. Chest 1987, 92, 440–446. [Google Scholar] [CrossRef]
- Ravaioli, S.; Campoccia, D.; Speziale, P.; Pietrocola, G.; Zatorska, B.; Maso, A.; Presterl, E.; Montanaro, L.; Arciola, C.R. Various biofilm matrices of the emerging pathogen Staphylococcus lugdunensis: Exopolysaccharides, proteins, eDNA and their correlation with biofilm mass. Biofouling 2020, 36, 86–100. [Google Scholar] [CrossRef] [PubMed]
- Campoccia, D.; Montanaro, L.; Ravaioli, S.; Pirini, V.; Cangini, I.; Arciola, C.R. Exopolysaccharide production by Staphylococcus epidermidis and its relationship with biofilm extracellular DNA. Int. J. Artif. Organs. 2011, 34, 832–839. [Google Scholar] [CrossRef] [PubMed]
- Arciola, C.R.; Collamati, S.; Donati, E.; Montanaro, L. A rapid PCR method for the detection of slime-producing strains of Staphylococcus epidermidis and S. aureus in periprosthesis infections. Diagn. Mol. Pathol. 2001, 10, 130–137. [Google Scholar] [CrossRef] [PubMed]
- Yokoi, K.J.; Kuzuwa, S.; Iwasaki, S.; Yamakawa, A.; Taketo, A.; Kodaira, K. Aureolysin of Staphylococcus warneri M accelerates its proteolytic cascade, and participates in biofilm formation. Biosci. Biotechnol. Biochem. 2016, 80, 1238–1242. [Google Scholar] [CrossRef][Green Version]
- Yokoi, K.; Kakikawa, M.; Kimoto, H.; Watanabe, K.; Yasukawa, H.; Yamakawa, A.; Taketo, A.; Kodaira, K.I. Genetic and biochemical characterization of glutamyl endopeptidase of Staphylococcus warneri M. Gene 2001, 281, 115–122. [Google Scholar] [CrossRef]
- Yokoi, K.J.; Kuzuwa, S.; Kondo, M.; Yamakawa, A.; Taketo, A.; Kodaira, K. Inactivation of the serine proteinase operon (proMCD) of Staphylococcus warneri M: Serine proteinase and cysteine proteases are involved in the autolysis. Gene 2013, 512, 240–246. [Google Scholar] [CrossRef] [PubMed]
- Yokoi, K.J.; Sugahara, K.; Iguchi, A.; Nishitani, G.; Ikeda, M.; Shimada, T.; Inagaki, N.; Yamakawa, A.; Taketo, A.; Kodaira, K. Molecular properties of the putative autolysin AtlWM encoded by Staphylococcus warneri M: Mutational and biochemical analyses of the amidase and glucosaminidase domains. Gene 2008, 416, 66–76. [Google Scholar] [CrossRef]
- Sun, Z.; Zhang, X.; Zhou, D.; Zhou, K.; Li, Q.; Lin, H.; Lu, W.; Liu, H.; Lu, J.; Lin, X.; et al. Identification of Three Clf-Sdr Subfamily Proteins in Staphylococcus warneri, and Comparative Genomics Analysis of a Locus Encoding CWA Proteins in Staphylococcus Species. Front. Microbiol. 2021, 12, 691087. [Google Scholar] [CrossRef]
- Saber, H.; Jasni, A.S.; Jamaluddin, T.Z.M.T.; Ibrahim, R. A Review of Staphylococcal Cassette Chromosome mec (SCCmec) Types in Coagulase-Negative Staphylococci (CoNS) Species. Malays. J. Med. Sci. 2017, 24, 7–18. [Google Scholar] [CrossRef]
- Kosecka-Strojek, M.; Sadowy, E.; Gawryszewska, I.; Klepacka, J.; Tomasik, T.; Michalik, M.; Hryniewicz, W.; Miedzobrodzki, J. Emergence of linezolid-resistant Staphylococcus epidermidis in the tertiary children’s hospital in Cracow, Poland. Eur. J. Clin. Microbiol. Infect. Dis. 2020, 39, 1717–1725. [Google Scholar] [CrossRef]
- Garbacz, K.; Wierzbowska, M.; Kwapisz, E.; Kosecka-Strojek, M.; Bronk, M.; Saki, M.; Międzobrodzki, J. Distribution and antibiotic-resistance of different Staphylococcus species identified by matrix assisted laser desorption ionization-time of flight mass spectrometry (MALDI-TOF MS) isolated from the oral cavity. J. Oral Microbiol. 2021, 13, 1983322. [Google Scholar] [CrossRef] [PubMed]
- Mirzaei, R.; Yousefimashouf, R.; Arabestani, M.R.; Sedighi, I.; Alikhani, M.Y. The issue beyond resistance: Methicillin-resistant Staphylococcus epidermidis biofilm formation is induced by subinhibitory concentrations of cloxacillin, cefazolin, and clindamycin. PLoS ONE 2022, 17, e0277287. [Google Scholar] [CrossRef] [PubMed] [PubMed Central]
- Ralhan, K.; Iyer, K.A.; Diaz, L.L.; Bird, R.; Maind, A.; Zhou, Q.A. Navigating Antibacterial Frontiers: A Panoramic Exploration of Antibacterial Landscapes, Resistance Mechanisms, and Emerging Therapeutic Strategies. ACS Infect. Dis. 2024, 10, 1483–1519. [Google Scholar] [CrossRef] [PubMed]
- Bright, R.; Hayles, A.; Wood, J.; Palms, D.; Brown, T.; Barker, D.; Vasilev, K. Surfaces Containing Sharp Nanostructures Enhance Antibiotic Efficacy. Nano Lett. 2022, 22, 6724–6731. [Google Scholar] [CrossRef] [PubMed]
- Mirzaei, R.; Alikhani, M.Y.; Arciola, C.R.; Sedighi, I.; Irajian, G.; Jamasbi, E.; Yousefimashouf, R.; Bagheri, K.P. Highly Synergistic Effects of Melittin with Vancomycin and Rifampin against Vancomycin and Rifampin Resistant Staphylococcus epidermidis. Front. Microbiol. 2022, 13, 869650. [Google Scholar] [CrossRef] [PubMed] [PubMed Central]
- Arciola, C.R.; Campoccia, D.; An, Y.H.; Baldassarri, L.; Pirini, V.; Donati, M.E.; Pegreffi, F.; Montanaro, L. Prevalence and antibiotic resistance of 15 minor staphylococcal species colonizing orthopedic implants. Int. J. Artif. Organs. 2006, 29, 395–401. [Google Scholar] [CrossRef] [PubMed]
- Lee, W.S.; Chen, F.L.; Jean, S.S.; Ou, T.Y. Staphylococcus warneri bacteremia complicating peritonitis in a patient with hyperthermic intraperitoneal chemotherapy (HIPEC). Int. J. Antimicrob. Agent 2017, 50, 196–197. [Google Scholar]
- Matsuoka, M.; Miyoshi, K.; Miura, T.; Tomono, S.; Ichiman, Y.; Shimada, J. Experimental haematogenous osteomyelitis of Staphylococcus warneri in mice. Staphylococci Staphylococcal Infect. 1994, 513–515. [Google Scholar]
- Lauková, A. Antagonistic activity of the rumen bacteria, Enterococcus faecium and Staphylococcus warneri. Vet. Med. 1993, 38, 267–274. [Google Scholar]
- White, D.G.; Harmon, R.J.; Langlois, B.E. Fluorogenic assay for differentiating Staphylococcus warneri and Staphylococcus hominis strains of bovine origin. J. Clin. Microbiol. 1990, 28, 602. [Google Scholar] [CrossRef]
- Wood, C.A.; Sewell, D.L.; Strausbaugh, L.J. Vertebral osteomyelitis and native valve endocarditis caused by Staphylococcus warneri. Diagn. Microbiol. Infect. Dis. 1989, 12, 261–263. [Google Scholar] [CrossRef] [PubMed]
- Diaconu, R.R.; Ponomariov, V.; Mirea, O.; Donoiu, I.; Istratoaie, O. An unusual case of infective endocarditis with Staphylococcus warneri, presenting as heart failure. Eur. J. Heart Fail. 2019, 21, 302–303. [Google Scholar]
- Abgrall, S.; Meimoun, P.; Buu-Hoi, A.; Couetil, J.P.; Gutmann, L.; Mainardi, J.L. Early prosthetic valve endocarditis due to Staphylococcus warneri with negative blood culture. J. Infect. 2001, 42, 166–169. [Google Scholar] [CrossRef]
- Bryan, C.S.; Parisi, J.T.; Strike, D.G. Vertebral osteomyelitis due to Staphylococcus warneri attributed to a Hickman catheter. Diagn. Microbiol. Infect. Dis. 1987, 8, 57–59. [Google Scholar] [CrossRef]
- Seabrook, G.R.; Schmitt, D.D.; Bandyk, D.F.; Edmiston, C.E.; Krepel, C.J.; Towne, J.B. Anastomotic femoral pseudoaneurysm: An investigation of occult infection as an etiologic factor. J. Vasc. Surg. 1990, 11, 629–634. [Google Scholar] [CrossRef]
- Center, K.J.; Reboli, A.C.; Hubler, R.; Rodgers, G.L.; Long, S.S. Decreased vancomycin susceptibility of coagulase-negative staphylococci in a neonatal intensive care unit: Evidence of spread of Staphylococcus warneri. J. Clin. Microbiol. 2003, 41, 4660–4665. [Google Scholar] [CrossRef] [PubMed]
- Turgut, M.; Alabaz, D.; Erbey, F.; Kokabas, E.; Erman, T.; Alhan, E.; Aksaray, N. Cerebrospinal fluid infections in children. Pediatr. Neurosurg. 2005, 41, 131–136. [Google Scholar] [CrossRef]
- Talon, R.; Montel, M.C.; Gandemer, G.; Viau, M.; Cantonnet, M. Lipolysis of pork fat by Staphylococcus warneri, S. Saprophyticus and Micrococcus varians. Appl. Microbiol. Biotechnol. 1993, 38, 606–609. [Google Scholar] [CrossRef]
- Metin, S.; Kubilay, A.; Onuk, E.E.; Didinen, B.I.; Yıldırım, P. First isolation of Staphylococcus warneri from cultured rainbow trout (Oncorhynchus mykiss) broodstock in Turkey. Bull. Eur. Assoc. Fish Pathol. 2015, 34, 165–174. [Google Scholar]
- Vasil, M.; Pecka-Kiełb, E.; Elečko, J.; Zachwieja, A.; Zawadzki, W.; Zigo, F.; Illek, J.; Farkašová, Z. Effects of udder infections with Staphylococcus xylosus and Staphylococcus warneri on the composition and physicochemical changes in cows milk. Pol. J. Vet. Sci. 2016, 19, 841–848. [Google Scholar] [CrossRef]
- Natalia, Q.P.; Cristina, R.T.; Germán, B.E. Lipolytic Effect of Staphylococcus warneri for Obtaining High-Quality Fishmeal from Fish Waste Fermentation. Waste Biomass Valorization 2022, 13, 2519–2530. [Google Scholar] [CrossRef]
- Talon, R.; Montel, M.C.; Berdague, J.L. Production of flavor esters by lipases of Staphylococcus warneri and Staphylococcus xylosus. Enzyme Microb. Technol. 1996, 19, 620–622. [Google Scholar] [CrossRef]
- Irlinger, F. Safety assessment of dairy microorganisms: Coagulase-negative staphylococci. Int. J. Food Microbiol. 2008, 126, 302–310. [Google Scholar] [CrossRef] [PubMed]
- Volpato, G.; Rodrigues, R.C.; Heck, J.X.; Ayub, M.A.Z. Effects of oxygen volumetric mass transfer coefficient and pH on lipase production by Staphylococcus warneri EX17. Biotechnol. Bioproc. E 2009, 14, 105–111. [Google Scholar] [CrossRef]
- Yele, V.U.; Desai, K. A new thermostable and organic solvent-tolerant lipase from Staphylococcus warneri; optimization of media and production conditions using statistical methods. Appl. Biochem. Biotechnol. 2015, 175, 855–869. [Google Scholar] [CrossRef]
- Volpato, G.; Filice, M.; de las Rivas, B.; Rodrigues, R.C.; Heck, J.X.; Fernandez-Lafuente, R.; Guisan, J.M.; Mateo, C.; Ayub, M.A. Purification, immobilization, and characterization of a specific lipase from Staphylococcus warneri EX17 by enzyme fractionating via adsorption on different hydrophobic supports. Biotechnol. Prog. 2011, 27, 717–723. [Google Scholar] [CrossRef]
- Volpato, G.; Filice, M.; Ayub, M.A.; Guisan, J.M.; Palomo, J.M. Single-step purification of different lipases from Staphylococcus warneri. J. Chromatogr. A 2010, 1217, 473–478. [Google Scholar] [CrossRef]
- Rech, F.R.; Volpato, G.; Ayub, M.A. Optimization of lipase production by Staphylococcus warneri EX17 using the polydimethylsiloxanes artificial oxygen carriers. J. Ind. Microbiol. Biotechnol. 2011, 38, 1599–1604. [Google Scholar] [CrossRef] [PubMed]
- Rech, F.R.; Volpato, G.; Ayub, M.A.Z. The effects of emulsified polydimethylsiloxane FG-10 on the oxygen transfer coefficient (kLa) and lipase production by Staphylococcus warneri EX17. J. Chem. Technol. Biotechnol. 2012, 87, 990–995. [Google Scholar] [CrossRef]
- De Abreu, L.; Fernandez-Lafuente, R.; Rodrigues, R.C.; Volpato, G.; Ayub, M.A.Z. Efficient purification-immobilization of an organic solvent-tolerant lipase from Staphylococcus warneri EX17 on porous styrene-divinylbenzene beads. J. Mol. Catal. B 2014, 99, 51–55. [Google Scholar] [CrossRef]
- Adebo, O.A.; Njobeh, P.B.; Mavumengwana, V. Degradation and detoxification of AFB1 by Staphylocococcus warneri, Sporosarcina spp. and Lysinibacillus fusiformis. Food Control 2016, 68, 92–96. [Google Scholar] [CrossRef]
- Pant, N.C.; Singh, R.; Gupta, V.; Chauhan, A.; Mavuduru, R.; Prabha, V.; Sharma, P. Contraceptive efficacy of sperm agglutinating factor from Staphylococcus warneri, isolated from the cervix of a woman with inexplicable infertility. Reprod. Biol. Endocrinol. 2019, 17, 85. [Google Scholar] [CrossRef] [PubMed]
- Pant, N.C.; Singh, R.; Chauhan, A.; Gupta, V.; Mavuduru, R.S.; Prabha, V.; Sharma, P. Contraceptive Sperm Agglutinating Proteins Identified in Staphylococcus warneri, Natural Microflora of an Infertile Woman. Indian J. Microbiol. 2019, 59, 51–57. [Google Scholar] [CrossRef] [PubMed]
- Wang, M.; Wang, C.; Yang, C.; Peng, L.; Xie, Q.; Zheng, R.; Dai, Y.; Liu, S.; Peng, X. Effects of Lactobacillus plantarum C7 and Staphylococcus warneri S6 on flavor quality and bacterial diversity of fermented meat rice, a traditional Chinese food. Food Res. Int. 2021, 150, 110745. [Google Scholar] [CrossRef]
- Hawari, F.L.; Almadea, T.; Hananingsih, K.; Baikuni, A.; Malik, A.; Arifianti, A.E.; Ramadon, D.; Tjampakasari, C.R. Development of Bacterial Cocktail of Strains Staphylococcus hominis, Staphylococcus warneri, Bacillus subtilis, and Micrococcus luteus as active ingredients for Skin Care Formula. Indones. J. Pharm. 2023, 34, 236. [Google Scholar]

| ID | Biochemical Identification | Ribo-Printer® Identification |
|---|---|---|
| cra2109 | S. warneri | S. aureus |
| cra2844 | S. warneri | S. haemolyticus |
| cra2520 | S. warneri | S. aureus |
| cra2525 | S. warneri | S. aureus |
| cra2981 | S. warneri | S. pasteuri |
| cra3488 | S. warneri | S. aureus |
| cra3882 | S. warneri | S. aureus |
| cra1302 | S. epidermidis | S. warneri |
| cra1371 | S. epidermidis | S. warneri |
| cra1372 | S. epidermidis | S. warneri |
| cra2845 | S. haemolyticus/S. warneri | S. warneri |
| cra3349 | S. warneri/E. aerogenes | S. warneri |
| cra3487 | S. aureus | S. warneri |
| cra3500 | CoNS | S. warneri |
| cra3665 | S. simulans | S. warneri |
| ID | POLY | IRI | IM |
|---|---|---|---|
| cra1302 | √ | IF | |
| cra1371 | √ | K | |
| cra1372 | √ | K | |
| cra1408 | √ | IF | |
| cra1463 | √ | IF | |
| cra1464 | √ | H | |
| cra1533 | √ | K | |
| cra1567 | - | ||
| cra1586 | √ | H | |
| cra1621 | - | ||
| cra1642 | √ | TG | |
| cra1665 | - | ||
| cra1760 | √ | H | |
| cra1880 | - | ||
| cra1912 | √ | H | |
| cra2005 | √ | H | |
| cra2017 | √ | √ | K |
| cra2125 | √ | √ | K |
| cra2126 | √ | - | |
| cra2191 | - | ||
| cra2210 | √ | √ | H |
| cra2222 | √ | H | |
| cra2255 | √ | H | |
| cra2285 | - | ||
| cra2370 | √ | IF | |
| cra2405 | √ | - | |
| cra2476-2 | √ | √ | K |
| cra2514 | √ | IF | |
| cra2545 | - | ||
| cra2558 | √ | H | |
| cra2776 | √ | H | |
| cra2796 | √ | H | |
| cra2805 | √ | H | |
| cra2845 | √ | H | |
| cra2921 | √ | IF | |
| cra2959 | √ | H | |
| cra2975 | √ | IF | |
| cra3060 | √ | H | |
| cra3064 | - | - | |
| cra3068 | √ | H | |
| cra3078 | √ | H | |
| cra3294 | √ | H | |
| cra3349 | √ | √ | H |
| cra3487 | √ | √ | A |
| cra3500 | √ | √ | H |
| cra3519 | - | ||
| cra3665 | √ | - | |
| cra4141 | - | √ | K |
| Pathology | Reference |
|---|---|
| Bacteremia | [18,20,86,107,108] |
| Native valve endocarditis | [18,22,23,26,39,45,46,47,48,49,50,51,109,110,111,112,113,114] |
| Orthopedic infection | [24,43,52,85,107,109,112,115,116] |
| Discitis | [21] |
| Botryomycosis | [53] |
| Neonatal and pediatric field | [10,20,112,117,118] |
| Cerebrospinal fluid shunt infections (CFS) | [1,2,4,54,55,118] |
| Bacterial ventriculitis | [56] |
| Sepsis | [11,57,58] |
| Urinary tract infection (UTI) | [59] |
| Meningitis | [60] |
| Medical devices (catheters and vascular graft) | [18,114,115] |
| Veterinary field | [30,31,34,67,69,109,110,111,119,120,121] |
| Food field | [6,37,40,64,122,123,124] |
Disclaimer/Publisher’s Note: The statements, opinions and data contained in all publications are solely those of the individual author(s) and contributor(s) and not of MDPI and/or the editor(s). MDPI and/or the editor(s) disclaim responsibility for any injury to people or property resulting from any ideas, methods, instructions or products referred to in the content. |
© 2024 by the authors. Licensee MDPI, Basel, Switzerland. This article is an open access article distributed under the terms and conditions of the Creative Commons Attribution (CC BY) license (https://creativecommons.org/licenses/by/4.0/).
Share and Cite
Ravaioli, S.; De Donno, A.; Bottau, G.; Campoccia, D.; Maso, A.; Dolzani, P.; Balaji, P.; Pegreffi, F.; Daglia, M.; Arciola, C.R. The Opportunistic Pathogen Staphylococcus warneri: Virulence and Antibiotic Resistance, Clinical Features, Association with Orthopedic Implants and Other Medical Devices, and a Glance at Industrial Applications. Antibiotics 2024, 13, 972. https://doi.org/10.3390/antibiotics13100972
Ravaioli S, De Donno A, Bottau G, Campoccia D, Maso A, Dolzani P, Balaji P, Pegreffi F, Daglia M, Arciola CR. The Opportunistic Pathogen Staphylococcus warneri: Virulence and Antibiotic Resistance, Clinical Features, Association with Orthopedic Implants and Other Medical Devices, and a Glance at Industrial Applications. Antibiotics. 2024; 13(10):972. https://doi.org/10.3390/antibiotics13100972
Chicago/Turabian StyleRavaioli, Stefano, Andrea De Donno, Giulia Bottau, Davide Campoccia, Alessandra Maso, Paolo Dolzani, Paulraj Balaji, Francesco Pegreffi, Maria Daglia, and Carla Renata Arciola. 2024. "The Opportunistic Pathogen Staphylococcus warneri: Virulence and Antibiotic Resistance, Clinical Features, Association with Orthopedic Implants and Other Medical Devices, and a Glance at Industrial Applications" Antibiotics 13, no. 10: 972. https://doi.org/10.3390/antibiotics13100972
APA StyleRavaioli, S., De Donno, A., Bottau, G., Campoccia, D., Maso, A., Dolzani, P., Balaji, P., Pegreffi, F., Daglia, M., & Arciola, C. R. (2024). The Opportunistic Pathogen Staphylococcus warneri: Virulence and Antibiotic Resistance, Clinical Features, Association with Orthopedic Implants and Other Medical Devices, and a Glance at Industrial Applications. Antibiotics, 13(10), 972. https://doi.org/10.3390/antibiotics13100972










